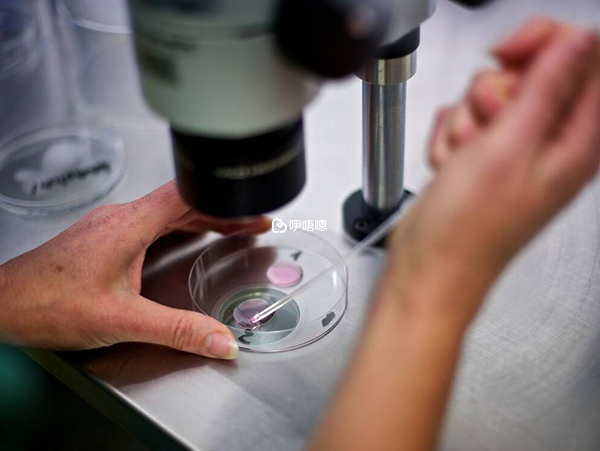

貴陽睿德邇醫院一般指貴州睿德邇婦產醫院(三級婦產醫院),地址位於貴州省貴陽市南明區遵義路2號,醫院能執行夫精人工授精技術、常規體外受精-胚胎移植技術、卵胞漿內單精子顯微注射技術等三項輔助生殖技術。試管移植凍胚的成功率在45%-50%左右,是當地不錯的試管嬰兒醫院。
貴陽睿德邇醫院是國泰康健醫療集團在南明區投資設立的一家以人類輔助生殖技術為特色的專科醫院,是經貴州省衛生和計劃生育委員會批准設立的一所集醫療、教學、科研和康復於一體的現代化三級婦產專科醫院。本文圍繞貴陽睿德邇醫院試管嬰兒技術、醫生、費用、成功率等展開,力求幫助更多不孕不育家庭在醫院選擇上提供參考。

貴陽睿德邇醫院(貴州睿德邇婦產醫院)生殖中心已通過貴州省衛生健康委批准,可開展人類輔助生殖技術(人工授精、試管嬰兒等),包括:夫精宮腔內人工授精、體外受精—胚胎移植、卵胞漿內單精子顯微注射技術、胚胎冷凍復甦技術、經皮附睪穿刺(PESA)和經皮睪丸精子抽吸術(TESA)、胚胎輔助孵化技術等。另外,還可開展女性不孕和男性不育的診斷篩查,習慣性流產診斷和優生優育諮詢。
貴陽睿德邇醫院位於中國貴州貴陽南明區遵義路2號,醫院以建設品牌專科醫院為目標,以生殖醫學為特色,致力於不斷提升醫療技術能力和服務水平。醫院設有生殖健康與不孕不育專業、婦科專業、計劃生育科、中醫婦科、麻醉科、藥劑科、檢驗科、放射科、B超室等25個一級診療科目。
貴陽睿德邇醫院生殖中心成立於2017年05月並已通過貴州省衛生健康委批准,可開展人類輔助生殖技術(人工授精、試管嬰兒等),擁有美國羅氏公司的全自動生化分析儀和全自動化學發光分析儀、全自動凝血分析儀、全自動五分類血液分析儀等大中型醫療裝置。並裝備有千、萬級層流淨化手術室和百級淨化工作臺等醫療設施。

目前該醫院匯聚了多位國內三甲公立醫院的權威專家和知名學科帶頭人,組成了一支強大的專家診療團隊。經過專業系統培訓,牢固樹立女性生殖功能保護意識,熟練掌握生殖外科手術。
高士友醫生是生殖中心總負責人/實驗室負責人/醫療院長,從事人類輔助生殖技術工作二十餘年,是國家第一屆生殖評審專家庫成員,並指導多家醫院生殖中心的籌建和執行,對於人類輔助生殖技術的執行和管理有十分豐富的經驗。

陳蘭醫生熟練運用宮腔內人工授精術、控制性超促排卵技術、經陰道B超引導下取卵術、胚胎移植術、經陰道B超引導下胚胎減滅術等技術。是生殖中心臨床負責人/生殖中心主任,從事婦產科臨床工作二十餘年,從事人類輔助生殖技術工作十餘年,完成體外受精-胚胎移植手術約1500例。

黃繪醫生擅長不孕不育及婦科內分泌疾病的診治、輔助生殖各項技術、反覆“試管嬰兒”失敗及複發性流產的處理。曾在國內外多家生殖醫學中心參加生殖醫學及輔助生殖技術專業培訓交流。領導市級多項科研課題,並獲得多項市級科技技術成果獎。

貴陽睿德邇醫院試管嬰兒費用囊括術前檢查費用、促排卵藥品費用以及胚胎移植手術費用,費用大致在20000元-120000元左右,受夫妻雙方的不同生育需求的影響。詳細如下表所示:
| 生育需求 | 費用預算 |
| 人工授精 | 12000-15000元/週期 |
| 第一代試管嬰兒 | 30000元-45000元/週期 |
| 第二代試管嬰兒 | 50000元-75000元/週期 |
| 第三代試管嬰兒 | 90000元-120000元/週期 |
| 供卵試管嬰兒 | 70000-90000元/週期 |
| 胚胎轉移 | 60000-85000元/次 |
貴陽睿德邇醫院試管嬰兒成功率大概在30%-65%左右,由於受到各種因素的影響,試管嬰兒的成功率都是各不相同的,但是並不說試管嬰兒的成功率一成不變,可以通過一定的方法來提高試管嬰兒的成功率。提高試管嬰兒成功率的方法有以下幾個方面:
到貴陽睿德邇醫院就醫的人群並不少,為了便於更多人瞭解貴陽睿德邇醫院好不好,特地收集了部分在該院就診夫妻的真實評價,供姐妹們參考。
雲南網友
截止到目前,貴州擁有試管嬰兒開展資質的醫院有13家,其中擁有三代試管嬰兒准入資質的醫院2家,為幫助更多人選擇合適的醫院,特整理2023年貴州試管嬰兒醫院排行榜(以准入時間排序)以供參考。
| 遵義醫學院附屬醫院 | 貴陽市兒童醫院 | 貴陽醫學院附屬醫院 | 貴州省人民醫院 |
| 貴州省婦幼 | 黔東南州中醫院 | 興義市人民醫院 | 貴陽市金陽醫院 |
| 畢節市人民醫院 | 遵義婦幼 | 六盤水市兒童醫院 | 安順人民醫院 |